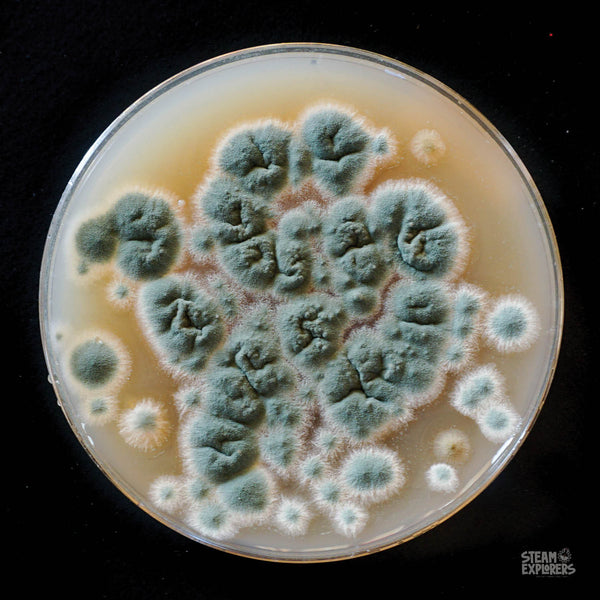

STEAM Explorers
Ewww this STEAM is cool!! In the STEAM Explorers Ewww edition we’re exploring awe-inspiring things from the world around us through hands-on science, technology, engineering, art, and math. Everyone will love making a digestive system model, growing mold, making noise putty, building a don’t touch this tool, sculpting hands, and so much more! You'll love the helpful standards-based learning, printables, and tools that make STEAM (science, technology, engineering, art, & math) exploration easy!
Ewww Ebook Unit Study by STEAM Explorers
Regular price
$24.99
Ewww this STEAM is cool!! In the STEAM Explorers Ewww edition we’re exploring awe-inspiring things from the world around us through hands-on science, technology, engineering, art, and math. Everyone will love making a digestive system model, growing mold, making noise putty, building a don’t touch this tool, sculpting hands, and so much more! You'll love the helpful standards-based learning, printables, and tools that make STEAM (science, technology, engineering, art, & math) exploration easy!
What's Inside the Ewww Ebook Unit Study by STEAM Explorers:
Inside every STEAM Explorers ebook are:
- Projects: Hands-on science, technology, engineering, art, and math projects
- Printables: Fun printables for independent learning and fun
- Recipes: Delicious recipes that have a learning spin
- Learning: Interesting reading that helps kids learn about our planet on every page
- Activity Calendar: A helpful calendar to make adding STEAM to your day simple and fun.
- Supplies List: A handy supplies list for the month that makes prep easy.
- BONUS! A coupon to save 25% on a monthly STEAM Explorers subscription. It's a great gift!! That's where you'll find a kid-safe online portal filled with helpful activity videos, teacher lesson plans, and more.